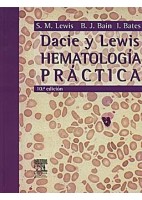
DACIE Y LEWIS HEMATOLOGIA PRACTICA

Lista de productos por editorial ELSEVIER
TECNICAS AVANZADAS EN REJUVENECIMIENTO FACIAL + 2 DVD-ROM + info
200,83 €-5% 211,40 €TECNICAS AVANZADAS EN REJUVENECIMIENTO FACIAL + 2 DVD-ROM
¡Oferta!MANUAL DE DIAGNOSTICO RADIOLOGICO VETERINARIO + info
122,08 €-5% 128,51 €MANUAL DE DIAGNOSTICO RADIOLOGICO VETERINARIO
¡Oferta!SLEISENGER & FORTRAN ENFERMEDADES DIGESTIVAS Y HEPATICAS (2 VOL.) + info
189,05 €-5% 199,00 €SLEISENGER & FORTRAN ENFERMEDADES DIGESTIVAS Y HEPATICAS (2 VOL.)
¡Oferta!CIRUGIA DE LAS VIAS BILIARES + info
128,34 €-5% 135,10 €CIRUGIA DE LAS VIAS BILIARES
¡Oferta!THE FOOT AND ANKLE IN RHEUMATOID ARTHRITIS + info
59,83 €-5% 62,98 €THE FOOT AND ANKLE IN RHEUMATOID ARTHRITIS
¡Oferta!DACIE Y LEWIS HEMATOLOGIA PRACTICA + info
189,62 €-5% 199,60 €DACIE Y LEWIS HEMATOLOGIA PRACTICA
¡Oferta!BIOESTADISTICA PARA NO ESTADISTICOS. BASES PARA INTERPRETAR ARTICULOS + info
54,81 €-5% 57,70 €BIOESTADISTICA PARA NO ESTADISTICOS. BASES PARA INTERPRETAR ARTICULOS
¡Oferta!CIRUGIA DEL TRACTO DIGESTIVO INFERIOR + info
143,16 €-5% 150,70 €CIRUGIA DEL TRACTO DIGESTIVO INFERIOR
¡Oferta!CIRUGIA OTOLOGICA Y OTONEUROLOGICA + info
143,16 €-5% 150,70 €CIRUGIA OTOLOGICA Y OTONEUROLOGICA
¡Oferta!ORTOPEDIA PEDIATRICA. MIEMBRO INFERIOR Y PELVIS + info
174,51 €-5% 183,70 €ORTOPEDIA PEDIATRICA. MIEMBRO INFERIOR Y PELVIS
¡Oferta!CIRUGIA HEPATICA Y DE LA HIPERTENSION PORTAL + info
143,16 €-5% 150,70 €CIRUGIA HEPATICA Y DE LA HIPERTENSION PORTAL
¡Oferta!ROTHMAN-SIMEONE LA COLUMNA (2 VOL) + info
162,73 €-5% 171,30 €ROTHMAN-SIMEONE LA COLUMNA (2 VOL)
¡Oferta!ATLAS DE DISECCION ANATOMOQUIRURGICA DE LA MUÑECA Y DE LA MANO + info
104,41 €-5% 109,90 €ATLAS DE DISECCION ANATOMOQUIRURGICA DE LA MUÑECA Y DE LA MANO
¡Oferta!DICCIONARIO DE FISIOTERAPIA + info
46,90 €-5% 49,37 €DICCIONARIO DE FISIOTERAPIA
¡Oferta!ANATOMIA BASADA EN LA RESOLUCION DE PROBLEMAS + info
51,30 €-5% 54,00 €ANATOMIA BASADA EN LA RESOLUCION DE PROBLEMAS
¡Oferta!OSTEOPATIA + info
77,82 €-5% 81,92 €OSTEOPATIA
¡Oferta!INMUNOLOGIA BASADA EN LA RESOLUCION DE PROBLEMAS + info
51,30 €-5% 54,00 €INMUNOLOGIA BASADA EN LA RESOLUCION DE PROBLEMAS
¡Oferta!CIRUGIA DEL HOMBRO Y DEL CODO + info
177,74 €-5% 187,10 €CIRUGIA DEL HOMBRO Y DEL CODO
¡Oferta!TRATAMIENTO DE LAS CICATRICES (DERMATOLOGIA COSMETICA) + info
104,78 €-5% 110,30 €TRATAMIENTO DE LAS CICATRICES (DERMATOLOGIA COSMETICA)
¡Oferta!MANUAL DE MEDICINA PARA PSIQUIATRAS + info
94,15 €-5% 99,10 €MANUAL DE MEDICINA PARA PSIQUIATRAS
¡Oferta!CIRUGIA DE LA PROSTATA + info
123,40 €-5% 129,90 €CIRUGIA DE LA PROSTATA
¡Oferta!PRIMER INTERVINIENTE EN EMERGENCIAS. MARCANDO LA DIFERENCIA + info
60,95 €-5% 64,16 €PRIMER INTERVINIENTE EN EMERGENCIAS. MARCANDO LA DIFERENCIA
¡Oferta!MANUAL DE DIAGNOSTICOS ENFERMEROS + info
33,15 €-5% 34,90 €MANUAL DE DIAGNOSTICOS ENFERMEROS
¡Oferta!RECURSOS HUMANOS PARA LA SALUD + info
54,24 €-5% 57,10 €RECURSOS HUMANOS PARA LA SALUD
¡Oferta!
Novedades
-

-

-

MINITORNILLOS. APLICACION DE MINITORNILLOS EN ORTODONCIA
MINITORNILLOS. APLICACION DE MINITORNILLOS EN ORTODONCIA
180,00 € -

-

-

-

-

FIRESTEIN Y KELLEY TRATADO DE REUMATOLOGIA (2 VOL.)
FIRESTEIN Y KELLEY TRATADO DE REUMATOLOGIA (2 VOL.)
380,00 €
LibreriaMedica.es
 Conócenos
Conócenos Estudiantes
 Estudiantes
Estudiantes